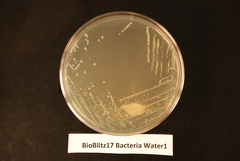
Rhizobium

©Benjamin Silva Ahumada, some rights reserved (CC-BY-NC)
©Finn McGhee, some rights reserved (CC-BY-NC)
©Finn McGhee, some rights reserved (CC-BY-NC)
©Finn McGhee, some rights reserved (CC-BY-NC)
©Charcos Companhia, some rights reserved (CC-BY-NC)
©Charcos Companhia, some rights reserved (CC-BY-NC)
©Eva Ullström, some rights reserved (CC-BY-NC)
©Eva Ullström, some rights reserved (CC-BY-NC)
©Eva Ullström, some rights reserved (CC-BY-NC)
©Eva Ullström, some rights reserved (CC-BY-NC)
©Finn McGhee, some rights reserved (CC-BY-NC)
©Gerrit Öhm, some rights reserved (CC-BY-NC)
©Gerrit Öhm, some rights reserved (CC-BY-NC)
©Gerrit Öhm, some rights reserved (CC-BY-NC)
©Gerrit Öhm, some rights reserved (CC-BY-NC)
©Gerrit Öhm, some rights reserved (CC-BY-NC)
©Finn McGhee, some rights reserved (CC-BY-NC)
©Finn McGhee, some rights reserved (CC-BY-NC)
©sea-kangaroo, some rights reserved (CC-BY-NC-ND)
©Tony Rebelo, some rights reserved (CC-BY-SA)
©Tony Rebelo, some rights reserved (CC-BY-SA)
©martli, some rights reserved (CC-BY-NC)
©Joe Holt, some rights reserved (CC-BY-NC)
©Joe Holt, some rights reserved (CC-BY-NC)
©Suzaan Kritzinger-Klopper, some rights reserved (CC-BY-NC)
©Suzaan Kritzinger-Klopper, some rights reserved (CC-BY-NC)
©Alejandro Alfredo Aguirre, some rights reserved (CC-BY-NC)
©Alejandro Alfredo Aguirre, some rights reserved (CC-BY-NC)
©Alejandro Alfredo Aguirre, some rights reserved (CC-BY-NC)
©Alejandro Alfredo Aguirre, some rights reserved (CC-BY-NC)
©Alejandro Alfredo Aguirre, some rights reserved (CC-BY-NC)
©Jared Shorma, some rights reserved (CC-BY)
©Jared Shorma, some rights reserved (CC-BY)
©Jared Shorma, some rights reserved (CC-BY)
©Jared Shorma, some rights reserved (CC-BY)
©Alejandro Alfredo Aguirre, some rights reserved (CC-BY-NC)
©Alejandro Alfredo Aguirre, some rights reserved (CC-BY-NC)
©Alejandro Alfredo Aguirre, some rights reserved (CC-BY-NC)
©Alejandro Alfredo Aguirre, some rights reserved (CC-BY-NC)
©Alejandro Alfredo Aguirre, some rights reserved (CC-BY-NC)
©David Laby, some rights reserved (CC-BY-NC)
©Bob Reed, some rights reserved (CC-BY-NC)
©Mario Vega Pérez, some rights reserved (CC-BY-NC)
©Ton Abad, some rights reserved (CC-BY-NC)
©BriK, some rights reserved (CC-BY-NC-SA)
©BriK, some rights reserved (CC-BY-NC-SA)
©mchaquis, some rights reserved (CC-BY-NC)
©mchaquis, some rights reserved (CC-BY-NC)
©ivank451, some rights reserved (CC-BY-NC)
©ivank451, some rights reserved (CC-BY-NC)
©ivank451, some rights reserved (CC-BY-NC)
©Braden J. Judson, some rights reserved (CC0)
©Braden J. Judson, some rights reserved (CC0)
©Braden J. Judson, some rights reserved (CC0)
©bioblitz-opunake2017, some rights reserved (CC-BY-NC)
©kthao, some rights reserved (CC-BY-NC)
©Susan J. Hewitt, some rights reserved (CC-BY-NC)
©Susan J. Hewitt, some rights reserved (CC-BY-NC)
©Susan J. Hewitt, some rights reserved (CC-BY-NC)
©deinonyco, some rights reserved (CC-BY-NC-SA)